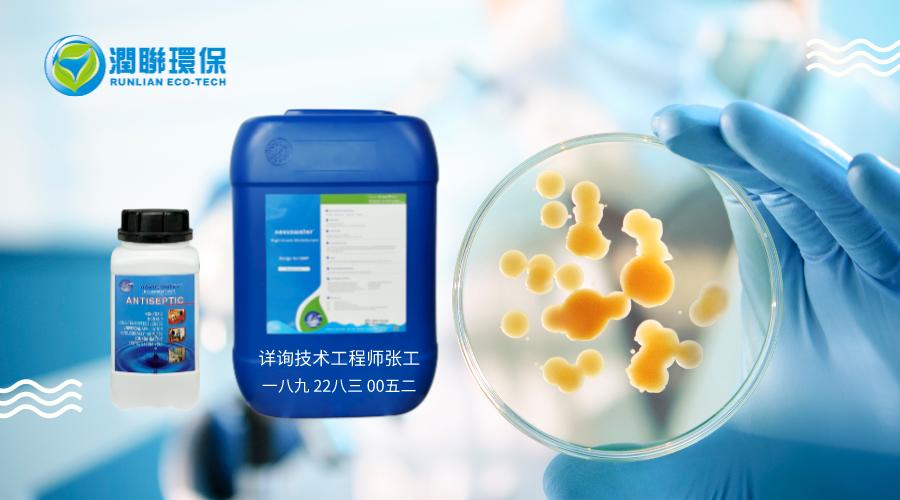
面包发霉一般是什么霉,面包发霉蒸一下还能吃吗

面包是一种营养丰富的食物,富含有淀粉、蛋白质和水份。对于霉菌来说,养分、水分及氧气充足的环境中是非常良好的生长环境,因此在面包在生产加工销售过程中,面包极易发生长毛变质。这主要是由霉菌引起的,主要包括青霉、黄曲霉、根霉等多种种类。
而面包含有的脂肪、蛋白质等成分为霉菌的繁殖提供良好的营养条件。霉菌利用孢子繁殖,霉菌孢子最适生长温度为20~35℃。当面包上出现霉斑时,孢子在面包上至少已经繁殖24小时了。霉菌还会引起面包内部发黏,面包内部会变得发黏发软,面包心灰暗,最后变成黏稠胶体物,将面包切开,可看见白色的菌丝体。

面包发霉除了储藏环境不利之外主要是由于企业在生产加工的过程中没有做好防护措置而引起的,主要与下列因素有关:
1.高温度湿度引起霉菌的繁殖:车间温度湿度过大,适宜霉菌的生长环境,容易导致车间一些角落会滋生霉菌:如管路,墙壁等等。
2.车间环境的污染:车间墙面、地面、设备工具、人员,设备内清洁不彻底,生产过程中的防护不当,洁净间水及杂物不及时清理,洁净工衣污染人员带入霉菌等。
3.车间通风不良:车间通风不良,会使霉菌孢子随意飘散,降落在加工设备、人员、成品上,直接或者间接的对加工的产品造成污染。
4.空气中浮游微生物污染:冷却、包装车间空气中浮游霉菌孢子会与灰尘粒子一起在车间内外落下,在室内会因为人员行走、操作和气流变化等而再度在空气中浮游,这些浮游的霉菌落在管道、食品表面、包材等表面,在适合于其生长的环境下孢子萌发,从而造成食品腐败变质。面包受微生物污染的关键危险点在于冷却和包装阶段,而此阶段是普通手段难以预防的空气途径污染。
如何防止面包发霉:
1.加强生产车间的通风,降低车间湿度。
2.做好车间设备人员等环境消毒,车间无水化,洁净间卫生器具规范管理。
3.冷却和包装阶段消毒尤为重要,加强车间的空气消毒,以及产品的包装消毒杀菌。
面包生产企业,想要做好消毒工作,必须选择合适的消毒杀菌产品。针对车间设备、工具、人员、管道以及车间内空气、包装的消毒。有关食品杀菌消毒技术人士建议使用欧洲原装进口的生态型灭菌产品--诺福novuswater,诺福novuswater基于欧洲原装食品级H2O2+活性胶质银离子的氧化灭菌原理杀菌高效并且无残留。据了解,诺福novuswater拥有丰富的成功经验,为国内上千家食品生产企业解决了微生物超标问题,诺福novuswater技术成熟、使用方便, 杀菌谱广,杀菌快,作用时间长,腐蚀性小的特点已经广泛应用于食品杀菌行业。
诺福novuswater特点:
1.是目前最安全、高效的消毒剂。作用完仅产生水和氧气,对人无害,不会腐蚀设备,无残留,诺福novuswater是通过氧原子的释放来进行杀毒,所以不会产生任何残留,完全环保。
2.应用广泛,可应用于设备、冷却车间内部环境、空气,以及包装的杀菌消毒工作,可以在上述面包加工的各个环节灭菌使用。
3.见效快,作用时间长,效果明显,能完全杀死有害菌。能从各个环境有效抑制霉菌滋生,提升保质时间。
4.光谱杀菌,不光能高效杀灭霉菌,并且对大肠杆菌,沙门氏菌等上百种有害菌有着高效的杀灭效果。
诺福novuswater来自比利时的高端技术母公司比利时IC集团(前身是比利时皇家IC集团)是目前唯一的真正无残留环保杀菌,保鲜,消毒产品。最重要的是诺福novuswater可根据企业特性量身打造最适合的灭菌服务方案,如有需要,欢迎联系。